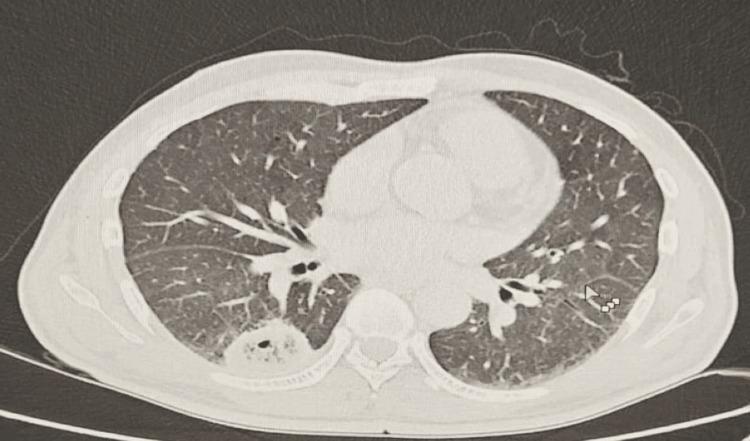
https://cdn.ncbi.nlm.nih.gov/pmc/blobs/8b77/12327917/cb1b99a74ef6/cureus-0017-00000087412-i02.jpg

侵袭性肺炎克雷伯菌导致同时性肝脓肿和肺脓肿:长期口服阿莫西林-克拉维酸成功治疗
Invasive Klebsiella pneumoniae Causing Concurrent Liver and Pulmonary Abscesses: Successful Management With Prolonged Oral Amoxicillin-Clavulanate.
作者信息
Ishag Mohammed Y, Alsuleimani Abdu Latif
机构信息
Internal Medicine, Nizwa Hospital, Nizwa, OMN.
Internal Medicine, Sudan Medical Specialization Board (SMSB), Khartoum, SDN.
出版信息
Cureus. 2025 Jul 7;17(7):e87412. doi: 10.7759/cureus.87412. eCollection 2025 Jul.
We report a rare case of a 59-year-old male patient with poorly controlled diabetes mellitus who presented with concurrent hepatic and pulmonary abscesses. Imaging revealed a large septated hepatic lesion and multiple bilateral pulmonary cavities. Cultures from blood and drained hepatic pus confirmed . Despite the lack of genomic testing, the clinical course was consistent with invasive syndrome (IKPS). The patient was treated successfully with prolonged intravenous and oral amoxicillin-clavulanate over six months, along with percutaneous drainage of the hepatic abscess. Follow-up imaging demonstrated near-complete resolution of both liver and lung lesions. This case highlights the importance of early source control and extended culture-guided antibiotic therapy in managing severe invasive infections in immunocompromised patients.
我们报告了一例罕见病例,一名59岁男性糖尿病患者,血糖控制不佳,同时出现肝脓肿和肺脓肿。影像学检查显示肝脏有一个大的分隔性病变以及双侧多个肺空洞。血液和引流的肝脓液培养结果证实了……。尽管缺乏基因组检测,但临床过程符合侵袭性……综合征(IKPS)。患者接受了为期六个月的延长静脉和口服阿莫西林 - 克拉维酸治疗,并对肝脓肿进行了经皮引流,治疗成功。随访影像学检查显示肝脏和肺部病变几乎完全消退。该病例强调了在免疫功能低下患者中,早期源头控制和延长的培养指导抗生素治疗在管理严重侵袭性……感染中的重要性。